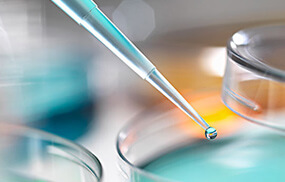

-
中国轻工业联合会的工业联合会的工业
2015年7月15日通过了中国轻工业联合会的工业联合会的工业联合会业联合会的工业联合会的工的工业联合会的工业联合会的鉴定…
2015/08/25 -
中国轻工业联合会的工业联合会的工业
2015年7月15日通过了中国轻工业联合会的工业联合会的工业联合会业联合会的工业联合会的工的工业联合会的工业联合会的鉴定…
2015/08/25
北京泛博化学股份有限公司是将北京泛博科技有限责任公司和沧州泛博精化有限公司的有效资源和业务整合、并吸收战略投资后设立的股份公司,主要从事裘皮、皮革、纺织化学品销售及技术推广,产品包括染料、助剂、功能性材料等共计600多个品种,产品性能处于行业领先水平。
泛博化学承继了北京泛博科技有限责任公司和沧州泛博精化有限公司多年来积累的销售渠道及客户资源,在全国范围内设有8个分支机构、26个代理商,并在俄罗斯、土耳其、乌克兰、韩国等国家设有代理商,销售网络遍及世界各地。
泛博化学视产品质量为企业生命,采用高效液相色谱仪、气相色谱仪、质谱仪、红外光度仪、紫外光度仪、电脑测色仪等国 内外尖端检测设备,确保产品性能稳定。
北京泛博化学股份有限公司拥有一支由众多行业专家组成的高素质技术服务团队,通过为客户提供全方位个性化技术解决方案,竭诚为客户服务,推动行业的技术进步。
查看更多